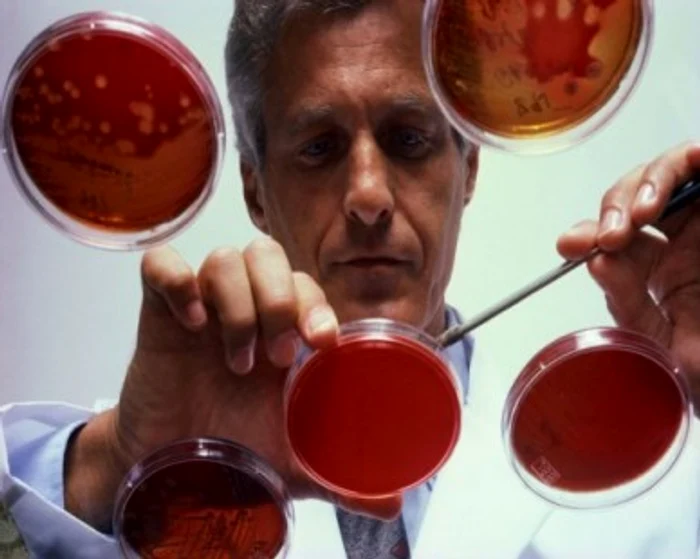
1 2 jpg jpeg

Cancerul de prostată, supradiagnosticat
(antigen prostatic specific) care ajută la
în stadii incipiente a determinat o
în ultimii 23 de ani, potrivit unui studiu realizat de oamenii de ştiinţă americani de la Institutul Naţional de Cancer. Prin urmare, cei mai mulţi bărbaţi au fost nevoiţi să suporte inutil neplăcerile tratamentului. Pe viitor, înainte de administrarea tratamentului, acest test trebuie repetat la intervale regulate de timp.
























